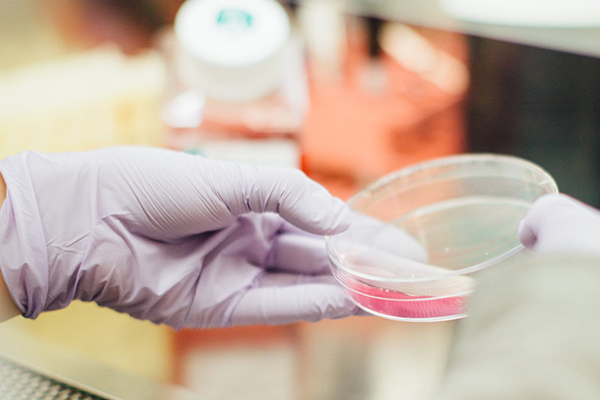

ВРАЧ Уролог-андролог
Получите консультацию и индивидуальное
лечение от врача уролога
Стоимость консультации:
По вопросам урологии — 2000 руб;
По вопросам андрологии — 2500 руб;
ЗАПИСАТЬСЯ НА ОНЛАЙН КОНСУЛЬТАЦИЮ
Для личной онлайн консультации со мной оставьте свои контактные данные и я Вам перезвоню в ближайшее время.
ВРАЧ Уролог-андролог
лечение от врача уролога
Стоимость: По вопросам урологии - 2000 руб; По вопросам андрологии - 2500 руб
ЗАПИСАТЬСЯ НА ОНЛАЙН КОНСУЛЬТАЦИЮ
Для личной онлайн консультации со мной оставьте свои контактные данные и я свяжусь с Вами в ближайшее время.
Прудий Степан сергеевич
Врач уролог-андролог, УЗИ
В 2018 году окончил Новгородский государственный университет имени Ярослава Мудрого по специальности «Лечебное дело», далее проходил обучение в клинической ординатуре по специальности «Урология» на базе Новгородской областной клинической больницы.
2020 год — получен сертификат по специальности Ультразвуковая диагностика.
2021 год — повышение квалификации «Современные аспекты клинической андрологии» на базе кафедры урологии ФГБОУ ВО «Первый Санкт-Петербургский Государственный Медицинский Университет Им. Акад. И.П. Павлова»
Опыт работы
2018г. — По настоящее время – врач-уролог ГОБУЗ НОКБ Новгородская областная клиническая больница
2019г- По настоящее время – врач-уролог ГОБУЗ ЦГКБ поликлиника №4
2020г — По настоящее время — врач-уролог МЦ «Альтернатива»
БОЛЕЕ
7 лет
в урологии
БОЛЕЕ
1000
консультаций в год
профессиональные навыки
Амбулаторный прием
Амбулаторный прием уролого-андрологических пациентов
Диагностика заболеваний
Диагностика урологических заболеваний (физикальная, лабораторная, рентгенологическая, КТ, УЗИ-диагностика)
Интерпретация обследований
Интерпретация полученных результатов обследований
Выбор методик лечения
Выбор методики консервативного, физиотерапевтического и оперативного лечения урологических и андрологических заболеваний
ПРЕИМУЩЕСТВА
01
Индивидуальный подход
Индивидуальный подход к каждому пациенту
02
ДЕТАЛЬНЫЙ РАЗБОР
Детальный разбор в каждом клиническом случае
03
КОНСЕРВАТИВНОЕ ЛЕЧЕНИЕ
Назначение консервативного лечения исходя из принципов наибольшей безопасности и эффективности
04
методики оперативного лечения
Выбор методики оперативного лечения исходя из принципов наибольшей безопасности и эффективности
ЗАБОЛЕВАНИЯ

Преждевременная эякуляция
Диагностика и лечение преждевременной эякуляции, рекомендации по выбору оперативного лечения при необходимости

Фимоз и гидроцеле
Диагностика и выбор методики оперативного лечения при других заболевания мочеполовой системы, таких как: фимоз, гидроцеле (водянка яичка), кисты яичка и придатка яичка, Болезнь Пейрони, Варикоцеле

Заболевания почек
Профилактика, диагностика, консервативное лечение и выбор методики оперативного лечения: Мочекаменной болезни (конкременты почек, мочеточников, мочевого пузыря и уретры), острый и хронический пиелонефрит, кисты почек

Мочевого пузыря
Профилактика, диагностика, консервативное лечение и выбор методики оперативного лечения острого и хронического цистита, стрессового недержания мочи, лейкоплакии мочевого пузыря, гиперактивности мочевого пузыря

Предстательной железы
Профилактика, диагностика и консервативное лечение острого и хронического простатита, гиперплазии (аденомы) предстательной железы. Диагностика рака предстательной железы

Органов мошонки
Профилактика, диагностика, консервативное лечение и выбор методики оперативного лечения: Орхоэпидидимит, баланит, баланопостит и др.
УСЛУГИ
ТЕСТЫ

Шкала количественной оценки мужской копулятивной функции.

Система суммарной оценки симптомов при хроническом простатите (СОС-ХП)
Оценка эректильного статуса у мужчин

Вопросы по половой функции (DAN-PSS)

Международная система суммарной оценки заболеваний предстательной железы IPSS/Qo

Опросник для оценки симптомов гиперактивного мочевого пузыря
СТАТЬИ
Баланопостит на головке. Причины, симптомы и тактика лечения
Баланопостит на головке — воспаление крайней плоти и головки полового члена. Причины включают инфекции, плохую гигиену, аллергии. Симптомы: зуд, покраснение, выделения. Лечение — гигиена, мази, антибиотики.
Баланопостит. Лечение воспаления: современные подходы и рекомендации
Баланопостит — воспалительное заболевание головки и крайней плоти полового члена. Современные методы лечения включают антисептики, местные препараты и, при необходимости, антибиотики по назначению врача.
Баланопостит. Принципы терапии и выбор схемы лечения
Баланопостит — воспалительное заболевание головки полового члена и крайней плоти. Принципы терапии включают устранение причины, местное лечение и, при необходимости, системную антибактериальную терапию.
Кандидозный баланопостит. Диагностика и тактика лечения
Кандидозный баланопостит — воспалительное заболевание головки и крайней плоти полового члена, вызванное грибами рода Candida. Диагностика включает осмотр, микроскопию мазков и посев. Лечение — антимикотики и коррекция факторов риска.
Кандидозный баланопостит. Клинические проявления и тактика лечения
Кандидозный баланопостит проявляется зудом, покраснением и налётом на головке полового члена. Лечение включает противогрибковые препараты и соблюдение гигиены для предотвращения рецидивов.
Баланит. Причины воспаления и современные подходы к терапии
Баланит — воспаление головки полового члена, часто вызванное инфекциями, нарушением гигиены или аллергией. Современные подходы к терапии включают местное лечение, устранение причины и профилактику рецидивов.
ОТЗЫВЫ
ЗАПИСАТЬСЯ НА ПРИЕМ
Для личной консультации со мной оставьте свои контактные данные и я свяжусь с Вами в ближайшее время.



